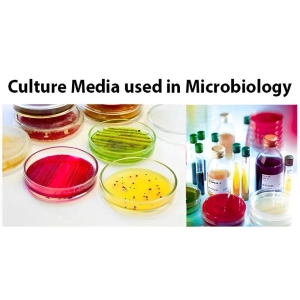
انواع محیط‌ های کشت باکتری

به فروشگاه اینترنتی آریاطب خوش آمدید!
دسته بندی ها
- تجهیزات کاردرمانی
- پزشکی خانگی
- پزشکی تخصصی
- پوست مو زیبایی
- تجهیزات و مواد آزمایشگاهی
- ابزار جراحی
-
مواد و تجهیزات دندانپزشکی
-
مواد دندانپزشکی
-
لوازم مصرفی دندانپزشکی
-
ابزار دندانپزشکی
-
تجهیزات دندانپزشکی
- لایت کیور دندانپزشکی
- دندان پزشکی دیجیتال
- اتوکلاو دندانپزشکی
- تجهیز مطب
- دوربین رادیوگرافی دیجیتال
- وی پک
- دستگاه جرمگیری
- آنگل دندانپزشکی
- هندپیس دندانپزشکی
- توربین دندانپزشکی
- ایرموتور دندانپزشکی
- موتور روتاری اندو
- موتور ایمپلنت
- اپکس فایندر | اپکس لوکیتور
- آمالگاماتور
- ایریگیشن دندانپزشکی | اندو اكتيواتور
- دستگاه پک اتوکلاو
-
واتر جت
-
مواد دندانپزشکی
- خدمات پزشکی
- تعمیرات
دسته بندی ها:
برند ها:
لندینگ:
محصولات: